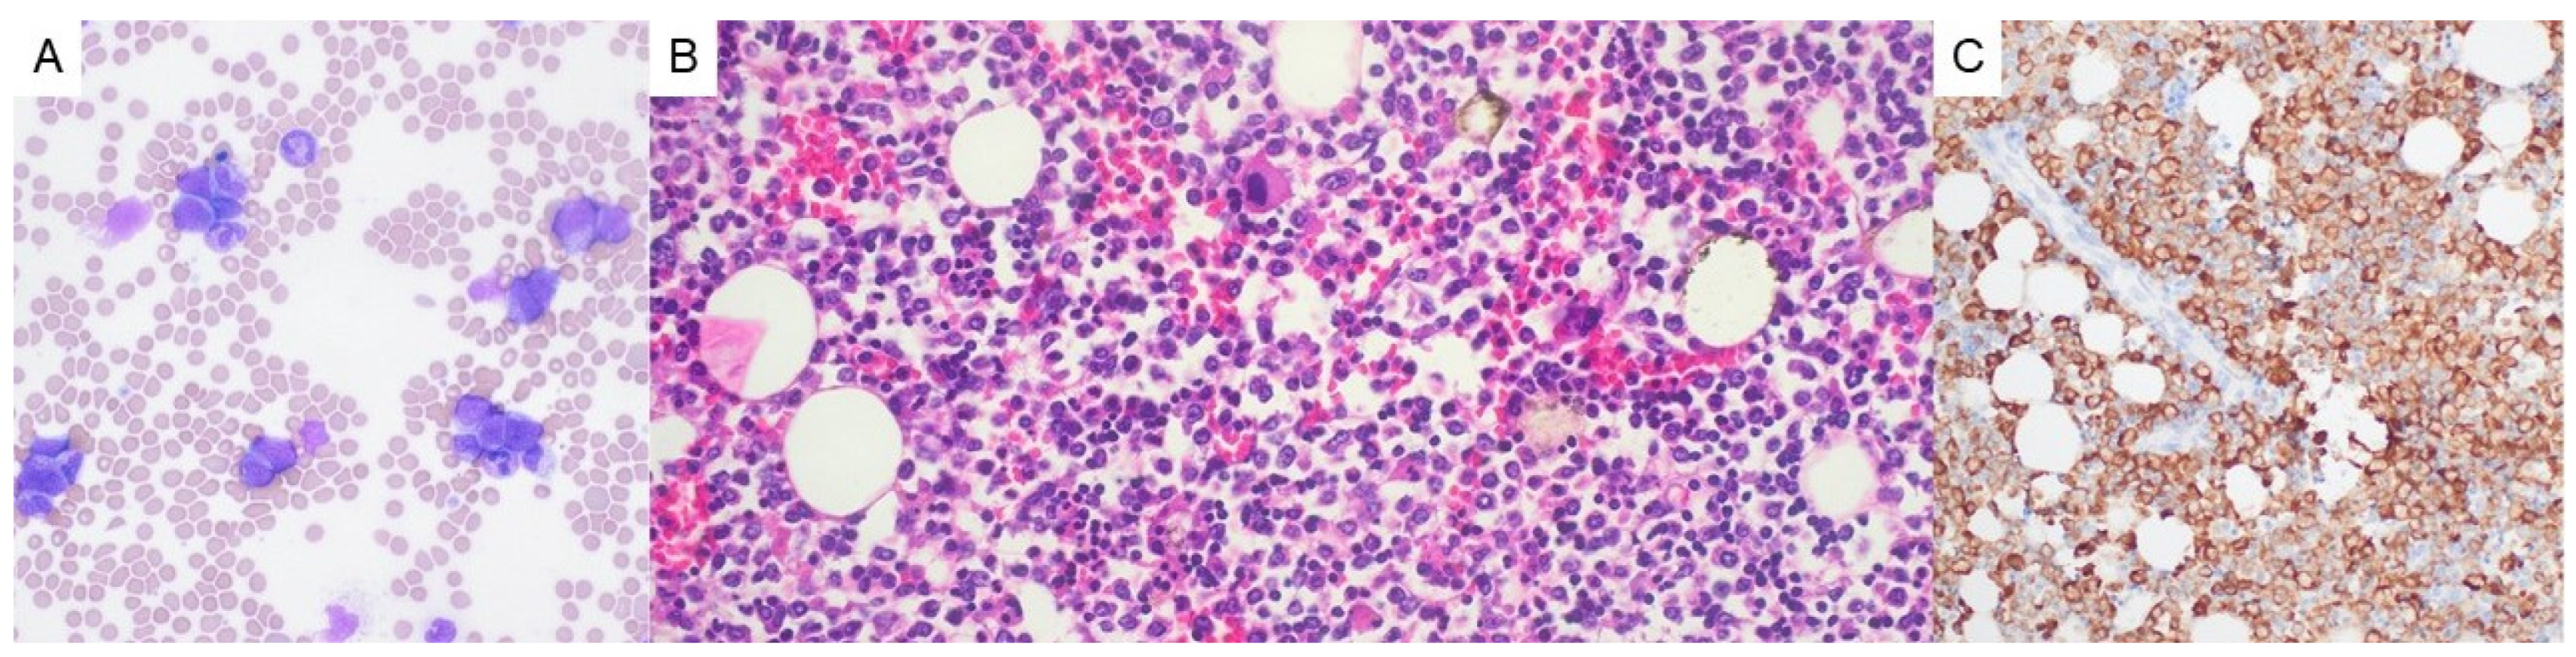
Hematolrep 17 00014 g003

Pure White Cell Aplasia, an Exceedingly Rare Complication of a Thymoma, and Immune Reconstitution Following Bone Marrow Recovery
Abstract
1. Background
2. Case Presentation
3. Discussion and Conclusions
Author Contributions
Funding
Institutional Review Board Statement
Informed Consent Statement
Data Availability Statement
Conflicts of Interest
References
- Marx, A.D.F.; Maron, E.M. Tumours of the thymus. In Thoracic Tumours [Internet], 5th ed.; WHO Classification of Tumours Editorial Board, Ed.; WHO Classification of Tumours Series; International Agency for Research on Cancer: Lyon, France, 2021; Volume 5. [Google Scholar]
- Weis, C.A.; Yao, X.; Deng, Y.; Detterbeck, F.C.; Marino, M.; Nicholson, A.G.; Huang, J.; Strobel, P.; Antonicelli, A.; Marx, A.; et al. The impact of thymoma histotype on prognosis in a worldwide database. J. Thorac. Oncol. 2015, 10, 367–372. [Google Scholar] [CrossRef]
- Cespedes Lopez, R.; Amutio Diez, E.; Martin Martitegui, X.; Balerdi Malcorra, A.; Insunza Oleaga, L.; Arzuaga-Mendez, J.; Moreno Gamiz, M.; Saiz Camin, M.; Aberasturi Plata, Y.; Garcia-Ruiz, J.C. Pure white cell aplasia an exceptional condition in the immunological conundrum of thymomas: Responses to immunosuppression and literature review. Clin. Case Rep. 2022, 10, e05742. [Google Scholar] [CrossRef] [PubMed]
- Uy, K.; Levin, E.; Mroz, P.; Li, F.; Shah, S. A Rare Complication of Thymoma: Pure White Cell Aplasia in Good’s Syndrome. Case Rep. Hematol. 2019, 2019, 1024670. [Google Scholar] [CrossRef] [PubMed]
- Becker, H.; Auman, K.; Claus, R.; von Bubnoff, N.; Sachs, U.J.; Waller, C.F. Sunitinib in the Treatment of Thymoma and Associated Autoimmune Neutropenia. JCO Precis. Oncol. 2017, 1, 1–7. [Google Scholar] [CrossRef]
- Fumeaux, Z.; Beris, P.; Borisch, B.; Sarasin, F.P.; Roosnek, E.; Dayer, J.M.; Chizzolini, C. Complete remission of pure white cell aplasia associated with thymoma, autoimmune thyroiditis and type 1 diabetes. Eur. J. Haematol. 2003, 70, 186–189. [Google Scholar] [CrossRef]
- Kobayashi, Y.; Ando, K.; Hata, T.; Imaizumi, Y.; Nagai, K.; Kamijyo, R.; Katoh, T.; Taguchi, J.; Itonaga, H.; Sato, S.; et al. Complete remission of pure white cell aplasia associated with thymoma after thymectomy and cyclosporine administration. Int. J. Hematol. 2019, 109, 346–350. [Google Scholar] [CrossRef]
- Yang, Y.; Chen, C.; Zheng, B.; Fan, L.; Chen, X.; Hu, M. Pure white cell aplasia before and after thymectomy in the rare conundrum of thymoma: A case report and review of the literature. Medicine 2024, 103, e36920. [Google Scholar] [CrossRef] [PubMed]
- Youssef, M.; Stratton, T.W.; Gallant, R.C.; Young, C.; Li, D.Y.; Piran, S. Pure White Cell Aplasia and Immune Thrombocytopenia after Thymoma Resection: A Case Report and Review of the Literature. Case Rep. Hematol. 2022, 2022, 8271069. [Google Scholar] [CrossRef] [PubMed]
- Desai, P.C.; Jones, P. Pure white cell aplasia in a patient with thymic carcinoma. Blood 2013, 122, 1340. [Google Scholar] [CrossRef] [PubMed]
- Curtis, B.R. Non-chemotherapy drug-induced neutropenia: Key points to manage the challenges. Hematol. Am. Soc. Hematol. Educ. Program 2017, 2017, 187–193. [Google Scholar] [CrossRef] [PubMed]
- Tsuda, K.; Yamanaka, K.; Kitagawa, H.; Akeda, T.; Naka, M.; Niwa, K.; Nakanishi, T.; Kakeda, M.; Gabazza, E.C.; Mizutani, H. Calcineurin inhibitors suppress cytokine production from memory T cells and differentiation of naive T cells into cytokine-producing mature T cells. PLoS ONE 2012, 7, e31465. [Google Scholar] [CrossRef]
- Proto, C.; Manglaviti, S.; Lo Russo, G.; Musca, M.; Galli, G.; Imbimbo, M.; Perrino, M.; Cordua, N.; Rulli, E.; Ballatore, Z.; et al. STYLE (NCT03449173): A Phase 2 Trial of Sunitinib in Patients With Type B3 Thymoma or Thymic Carcinoma in Second and Further Lines. J. Thorac. Oncol. 2023, 18, 1070–1081. [Google Scholar] [CrossRef] [PubMed]
- Thomas, A.; Rajan, A.; Berman, A.; Tomita, Y.; Brzezniak, C.; Lee, M.J.; Lee, S.; Ling, A.; Spittler, A.J.; Carter, C.A.; et al. Sunitinib in patients with chemotherapy-refractory thymoma and thymic carcinoma: An open-label phase 2 trial. Lancet Oncol. 2015, 16, 177–186. [Google Scholar] [CrossRef] [PubMed]
- Remon, J.; Girard, N.; Mazieres, J.; Dansin, E.; Pichon, E.; Greillier, L.; Dubos, C.; Lindsay, C.R.; Besse, B. Sunitinib in patients with advanced thymic malignancies: Cohort from the French RYTHMIC network. Lung Cancer 2016, 97, 99–104. [Google Scholar] [CrossRef] [PubMed]
- Sun, H.Y.; Singh, N. Immune reconstitution inflammatory syndrome in non-HIV immunocompromised patients. Curr. Opin. Infect. Dis. 2009, 22, 394–402. [Google Scholar] [CrossRef] [PubMed]

Disclaimer/Publisher’s Note: The statements, opinions and data contained in all publications are solely those of the individual author(s) and contributor(s) and not of MDPI and/or the editor(s). MDPI and/or the editor(s) disclaim responsibility for any injury to people or property resulting from any ideas, methods, instructions or products referred to in the content. |
© 2025 by the authors. Licensee MDPI, Basel, Switzerland. This article is an open access article distributed under the terms and conditions of the Creative Commons Attribution (CC BY) license (https://creativecommons.org/licenses/by/4.0/).
Share and Cite
George, G.V.; Uy, J.C.; Mariano, J.L.; Jacob-Leonce, M.; Syposs, C.R. Pure White Cell Aplasia, an Exceedingly Rare Complication of a Thymoma, and Immune Reconstitution Following Bone Marrow Recovery. Hematol. Rep. 2025, 17, 14. https://doi.org/10.3390/hematolrep17020014
George GV, Uy JC, Mariano JL, Jacob-Leonce M, Syposs CR. Pure White Cell Aplasia, an Exceedingly Rare Complication of a Thymoma, and Immune Reconstitution Following Bone Marrow Recovery. Hematology Reports. 2025; 17(2):14. https://doi.org/10.3390/hematolrep17020014
Chicago/Turabian StyleGeorge, Giby V., J. C. Uy, John L. Mariano, Marisa Jacob-Leonce, and Chauncey R. Syposs. 2025. "Pure White Cell Aplasia, an Exceedingly Rare Complication of a Thymoma, and Immune Reconstitution Following Bone Marrow Recovery" Hematology Reports 17, no. 2: 14. https://doi.org/10.3390/hematolrep17020014
APA StyleGeorge, G. V., Uy, J. C., Mariano, J. L., Jacob-Leonce, M., & Syposs, C. R. (2025). Pure White Cell Aplasia, an Exceedingly Rare Complication of a Thymoma, and Immune Reconstitution Following Bone Marrow Recovery. Hematology Reports, 17(2), 14. https://doi.org/10.3390/hematolrep17020014

